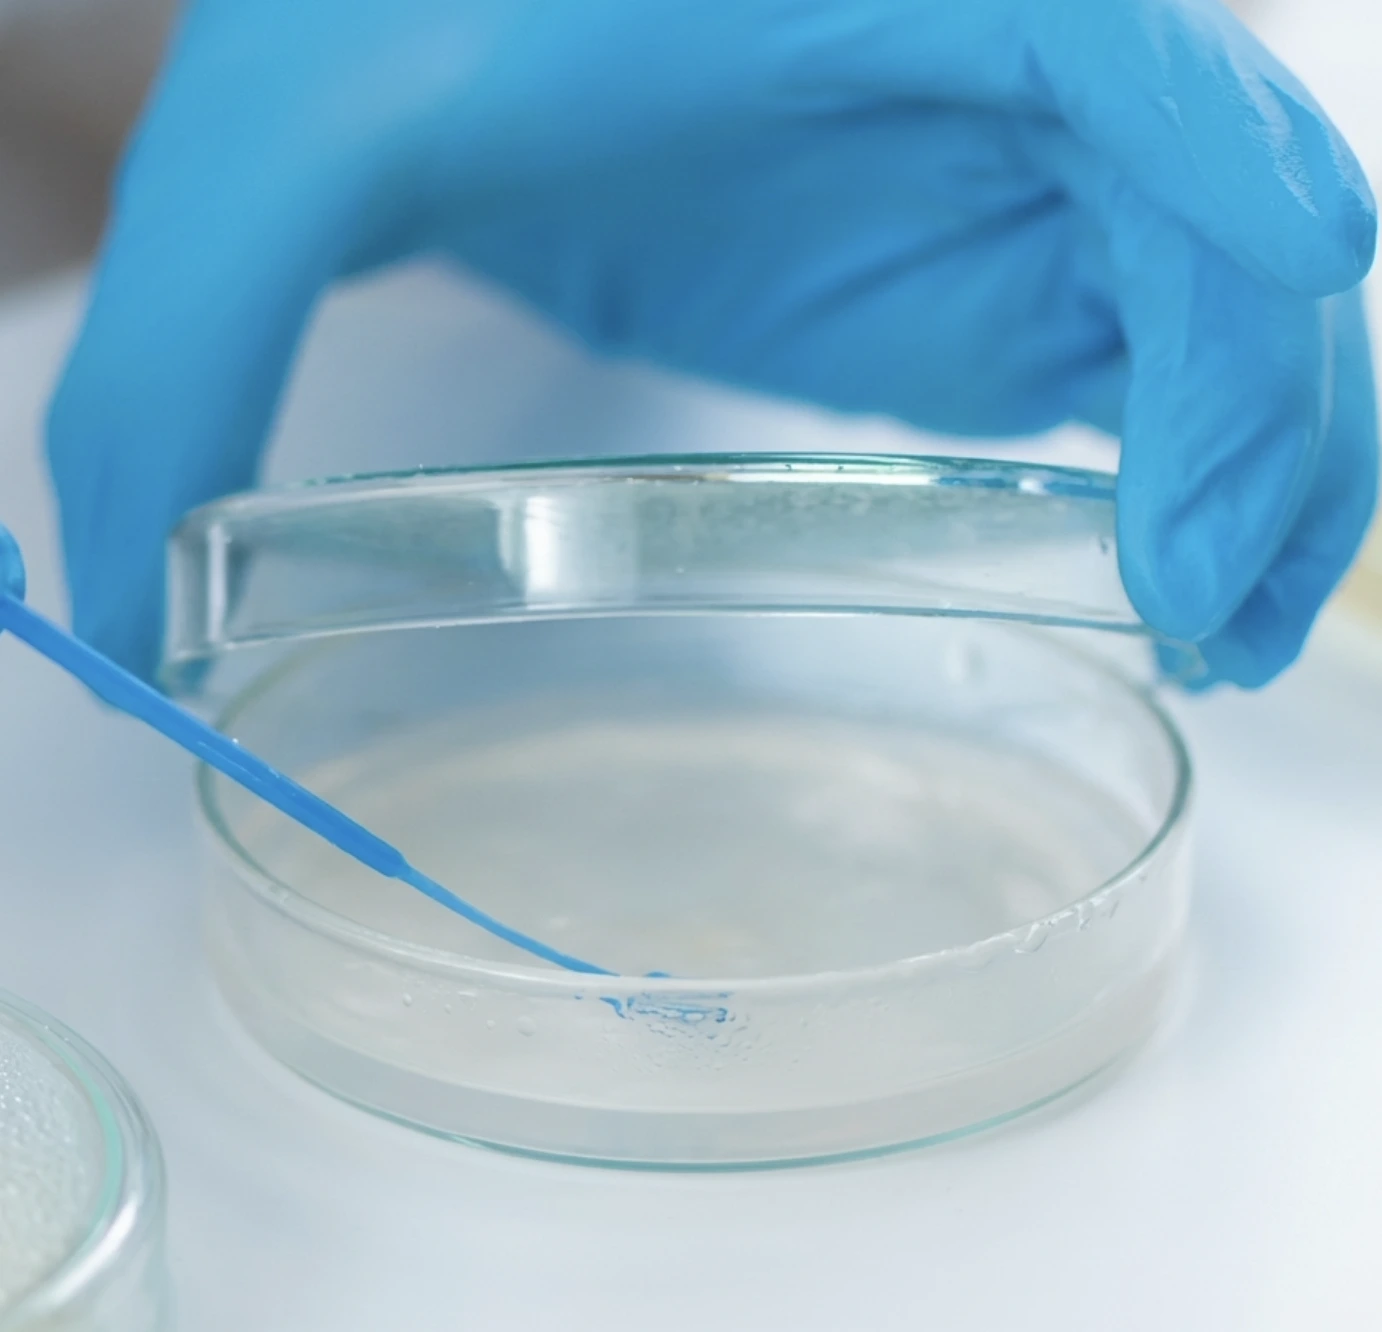

Наночастицы водного раствора диоксида кремния (кизельзоль) обладают выраженным отрицательным дзета-потенциалом (в диапазоне порядка −10…−25 мВ), который инициирует мгновенное электростатическое притяжение к положительно заряженным сегментам белковых цепей желатина и собственных белков сырья. В результате классическая бинарная оклейка сока силиказолем и желатином запускает процесс необратимой коацервации, формируя плотные пространственные агломераты.
На макроуровне это приводит к радикальному изменению реологии системы. Сформированные флокулы не зависают в объеме, а стремительно седиментируют, образуя жесткий осадок. Быстрое разделение фаз минимизирует время нахождения сока в буферных емкостях, оптимизируя оборачиваемость танков и снижая энергозатраты на поддержание низких температур.
Введение кремнезоля в схему совместно с желатином позволяет заметно сократить время формирования стабильного осадка по сравнению с моно‑оклейкой желатином, вплоть до нескольких часов в зависимости от свойств сырья и режима обработки.

Критическим фактором эффективности золя диоксид кремния является его стабильность при низких значениях pH (3.0–4.0), характерных для фруктовых экстрактов. В отличие от многих других осветлителей, наночастицы SiO2 в коллоидном растворе сохраняют высокий рабочий отрицательный поверхностный заряд благодаря тому, что изоэлектрическая точка чистого диоксида кремния находится на экстремально низком уровне (около pH 2.0). Это исключает риск гелирования (самопроизвольной коагуляции) самого реагента до момента контакта с целевыми протеинами соков.
Эффективная очистка и снятие стерического препятствия требуют точного сдвига дзета-потенциала системы от исходных нестабильных значений ближе к нулю. Полная нейтрализация заряда снимает электростатическое отталкивание между коллоидами, запуская цепную реакцию агломерации и выпадения в осадок.
Параметры механизма:

Внедрение в производственную технологию коллоидных силиказолей позволяет решить проблему таргетированного удаления мутеобразующих протеинов HAP (haze active proteins). Силиказоль проявляет высочайшую селективность именно к гидрофобным фракциям белков с определенной молекулярной массой, которые вступают в реакции с полифенолами, образуя видимую взвесь. Применяя силиказоль против белкового помутнения, технолог выборочно извлекает из раствора только триггеры нестабильности, сохраняя при этом органолептический профиль напитка.

В классических системах очистки соков существует высокий риск остаточного белкового помутнения, возникающего из-за избытка желатина, которому не хватило природных растительных танинов для реакции. В данном случае коллоидный кремнезоль выполняет функцию высокоемкого буфера. Он безотказно связывает весь свободный белок, выполняя роль "искусственного танина".
Точная дозировка золя диоксида кремния при осветлении напитков рассчитывается на основе стехиометрических пропорций. Отклонение от выверенного баланса ведет к смещению изоэлектрической точки и неполному осаждению, однако при соблюдении регламента система гарантирует формирование кристально чистого супернатанта. Происходит полная нейтрализация избыточного желатина.

Эффективность контактной адсорбции напрямую зависит от нанометрового калибра частиц. Профессиональный золь диоксида кремния для соков характеризуется экстремально высокой удельной площадью поверхности, что обеспечивает максимальное количество активных центров (силанольных групп) на единицу объема реагента.
Математическая зависимость адсорбционной емкости от размера частиц диктует высокую скорость связывания молекул. Чем больше площадь контакта, тем плотнее упаковывается молекулярный каркас флокулы, что напрямую влияет на кинетику седиментации и скорость осветления всего объема буферного танка.
Предварительная обработка кизельзолем критически важна для подготовки сока к тангенциальной фильтрации. Качественное устранение взвесей и коллоидов приводит к радикальному снижению индекса загрязнения (фоулинга) SDI. Органический фоулинг — главная причина падения гидравлической проницаемости мембран, требующая их частой химической регенерации.
Снижение мутности на входе позволяет мембранным установкам работать на максимальной производительности без риска кольматации пор. Это напрямую продлевает жизненный цикл полимерных мембран и снижает затраты на агрессивные химикаты для CIP-моек.
Предварительная обработка кремнезолем позволяет существенно снизить мутность сильно загрязнённых соков (порядка сотен NTU) до единичных значений NTU, достаточных для эффективной работы мембранных систем.

На микроуровне поверхность наночастиц суспензии покрыта высокореакционноспособными функциональными Si-OH группами. Химическая роль этих групп заключается в формировании прочных водородных связей с гидроксилами полифенолов и полярными участками полипептидов.
Связывание происходит не хаотично, а с образованием жесткого единого пространственного каркаса. Полифенольный комплекс надежно фиксируется внутри флокулы, что препятствует его дальнейшему окислению и деградации цвета готового продукта.
Фактические параметры механизма:

Интегрируясь в структуру белково-полифенольного флокула, наночастицы SiO2 выступают в роли микроскопического утяжелителя. Высокая плотность диоксида кремния экспоненциально увеличивает скорость седиментации согласно закону Стокса. Применяя кремнезоль для осветления сока, предприятие добивается максимального физического сжатия осадка.
Калькуляция сохраненного объема показывает, что радикальное уплотнение осадка высвобождает значительную часть продукта, который ранее списывался в потери.


Локализация производственной базы и полный контроль над процессом синтеза делают завод "РусСилика" стратегическим партнером для предприятий пищевой промышленности. Наша инфраструктура позволяет синтезировать золь кремнезема с узким распределением частиц по размерам, обеспечивая абсолютную чистоту продукта – отсутствие тяжелых металлов и сторонних примесей, что критически важно для применения в технологии осветления соков.
Мощности "РусСилика" покрывают потребности самых крупных переработчиков, предоставляя продукт с выверенной концентрацией и стабильным pH.
Запросите образцы RUSSOL для проведения лабораторных и промышленных испытаний, чтобы на практике оценить кинетику седиментации и реологию осадка на вашем сырье.

Адсорбент RUSSOL представляет собой стабилизированную водную дисперсию наночастиц аморфного кремнезема пищевого уровня чистоты. Его физико-химический профиль спроектирован специально для преодоления электростатического отталкивания коллоидов в агрессивных кислых средах фруктовых экстрактов (pH 3.0–4.0).
| Параметр | Значение | Технологическое значение для производства |
| Концентрация активного вещества (SiO2) | до 30% | Оптимальный баланс между вязкостью реагента и эффективностью коацервации. |
| Диаметр наночастиц | 10–30 нм | Гарантирует таргетное связывание мутеобразующих белков HAP. |
| Удельная площадь поверхности | 200–500 м²/г | Максимизирует количество активных силанольных (Si-OH) групп для водородных связей. |
| Дзета-потенциал | от -10 до -25 мВ | Обеспечивает мощный электростатический заряд для мгновенной реакции с желатином. |
| Физическая плотность частиц | ~2.2 г/см³ | Выступает утяжелителем (закон Стокса), радикально ускоряя гравитационное уплотнение. |
| Изоэлектрическая точка (чистый SiO2) | ~pH 2.0 | Исключает аутокоагуляцию золя в сильно кислых фруктовых средах (pH < 3.0). |
Строгий контроль гранулометрического состава на этапе синтеза исключает присутствие микрочастиц, обеспечивая предсказуемую реологию осадка и абсолютную прозрачность готового продукта.
Внедрение таргетной флокуляции напрямую влияет на финансовые показатели предприятия.
| Проблема на производстве | Решение с помощью RUSSOL | Экономическая выгода (ROI) |
| Высокие потери продукта с осадком | Увеличенное физическое сжатие осадка за счет плотности наночастиц SiO2. | Выход готового продукта (товарного сока) увеличивается на 2–5% с каждой тонны. Максимизация прибыли. |
| Органический фоулинг ультрафильтрационных мембран | Падение мутности до уровня единиц NTU перед подачей на тангенциальную фильтрацию. | Жизненный цикл мембран возрастает на 25–40%. Снижение расходов на химикаты для CIP-моек. |
| Вторичное коллоидное помутнение в таре | Селективная экстракция мутеобразующих протеинов (15–31 кДа) и связывание полифенолов. | Сохранение качества, предотвращение убытков от возврата партий готовой продукции. |
| Длительный цикл осаждения (18–24 часа) | Ускорение кинетики седиментации до 2–6 часов. | Энергосбережение (снижение нагрузки на системы охлаждения (чиллеры)). Ускоренная оборачиваемость буферных танков. |
| Высокие затраты на вспомогательные материалы | Формирование кристально чистого супернатанта на этапе буферной емкости. | Снижение расхода кизельгура и картонов. Минимальная себестоимость фильтрации, рост рентабельности. |
Использование RUSSOL переводит процесс очистки в инструмент генерации добавочной стоимости. Интеграция адсорбента гарантирует снижение брака и оптимизацию расходов OPEX.
Предприятие "РусСилика" реализует концепцию безотходного синтеза в строгом соответствии с международными ESG-стандартами.
В производстве золя диоксида кремния для соков не применяются токсичные растворители, тяжелые металлы или модификаторы поверхности на основе алюминия. Это позволяет нам поставлять на рынок продукт пищевого уровня.
Логистическая и инженерная инфраструктура "РусСилика" адаптирована под бесперебойные крупнотоннажные поставки (IBC-контейнеры, автоцистерны). Процесс внедрения начинается с аудита текущей технологии стабилизации соков: наши инженеры-химики анализируют исходную мутность, профиль pH и содержание пектина в вашем сырье, после чего рассчитывают точные стехиометрические пропорции комплекса. Наш кремнезоль для осветления сока легко интегрируется в существующие автоматизированные узлы дозирования без необходимости капитальной модернизации цеха.
Запросите образцы RUSSOL для лабораторных испытаний — убедитесь в увеличении скорости седиментации и снижении индекса фоулинга (SDI) на собственной сырьевой базе.








© 2020-2024 ООО "РусСилика" ОГРН 1205500027710, ИНН 5501267734, КПП 524901001.
Вся информация на сайте носит справочный характер и не является публичной офертой, определяемой статьей 437 ГК РФ.